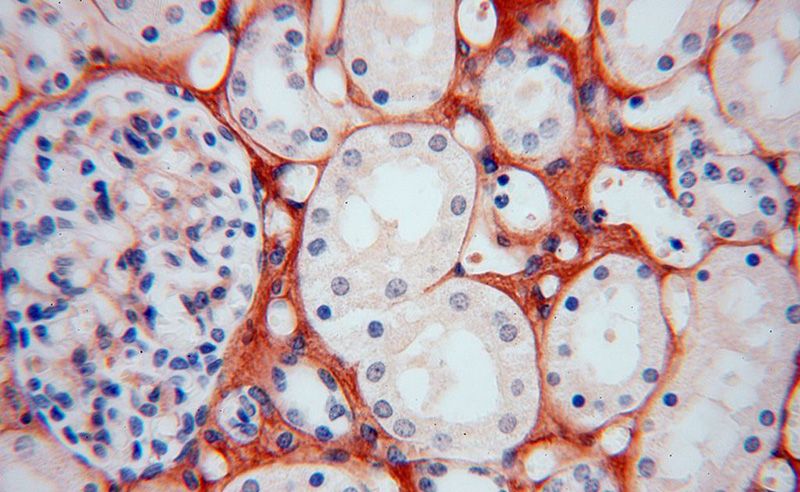
Immunohistochemical of paraffin-embedded human kidney using Catalog No:109438(COL6A1 antibody) at dilution of 1:100 (under 40x lens)

-
Product Name
Collagen Type VI antibody
- Documents
-
Description
Collagen Type VI Rabbit Polyclonal antibody. Positive WB detected in human skeletal muscle tissue, human heart tissue. Positive IP detected in mouse heart tissue. Positive IHC detected in human kidney tissue, human heart tissue, human liver tissue, human lung tissue, human ovary tissue, human placenta tissue, human skin tissue, human spleen tissue, human testis tissue. Positive IF detected in mouse skeletal muscle tissue. Observed molecular weight by Western-blot: 140 kDa
-
Tested applications
ELISA, WB, IHC, IF, IP
-
Species reactivity
Human,Mouse,Rat; other species not tested.
-
Alternative names
COL6A1 antibody; collagen 6A1 antibody; Collagen alpha 1(VI) chain antibody; collagen antibody; type VI antibody; alpha 1 antibody; OPLL antibody
-
Isotype
Rabbit IgG
-
Preparation
This antibody was obtained by immunization of Collagen Type VI recombinant protein (Accession Number: NM_001848). Purification method: Antigen affinity purified.
-
Clonality
Polyclonal
-
Formulation
PBS with 0.02% sodium azide and 50% glycerol pH 7.3.
-
Storage instructions
Store at -20℃. DO NOT ALIQUOT
-
Applications
Recommended Dilution:
WB: 1:500-1:5000
IP: 1:200-1:2000
IHC: 1:20-1:200
IF: 1:20-1:200
-
Validations

human skeletal muscle tissue were subjected to SDS PAGE followed by western blot with Catalog No:109438(COL6A1 antibody) at dilution of 1:500

Immunohistochemical of paraffin-embedded human kidney using Catalog No:109438(COL6A1 antibody) at dilution of 1:100 (under 10x lens)
Immunohistochemical of paraffin-embedded human kidney using Catalog No:109438(COL6A1 antibody) at dilution of 1:100 (under 40x lens)

IF result of anti-COL6A1 (Catalog No:109438, 1:500) with PFA fixed mouse skeletal muscle tissue by Dr. Daniel Kopinke.

IP Result of anti-COL6A1 (IP:Catalog No:109438, 4ug; Detection:Catalog No:109438 1:500) with mouse heart tissue lysate 8000ug.
-
Background
Type VI Collagen is a major structural component of microfibrils. Type VI Collagen was found to be present throughout the connective tissue and in the extracellular matrix of cultured fibroblasts (PMID: 6723253). It is a heterotrimer composed of three different chains: alpha-1(VI), alpha-2(VI), and alpha-3(VI) or alpha-5(VI) or alpha-6(VI). The alpha-1(VI) chain is encoded by COL6A1 gene. Mutations in this gene result in Bethlem myopathy and Ullrich congenital muscular dystrophy.
-
References
- Paez-Cortez J, Krishnan R, Arno A. A new approach for the study of lung smooth muscle phenotypes and its application in a murine model of allergic airway inflammation. PloS one. 8(9):e74469. 2013.
- Zhu YP, Wan FN, Shen YJ, Wang HK, Zhang GM, Ye DW. Reactive stroma component COL6A1 is upregulated in castration-resistant prostate cancer and promotes tumor growth. Oncotarget. 6(16):14488-96. 2015.
- Wan F, Wang H, Shen Y. Upregulation of COL6A1 is predictive of poor prognosis in clear cell renal cell carcinoma patients. Oncotarget. 6(29):27378-87. 2015.
Related Products / Services
Please note: All products are "FOR RESEARCH USE ONLY AND ARE NOT INTENDED FOR DIAGNOSTIC OR THERAPEUTIC USE"
